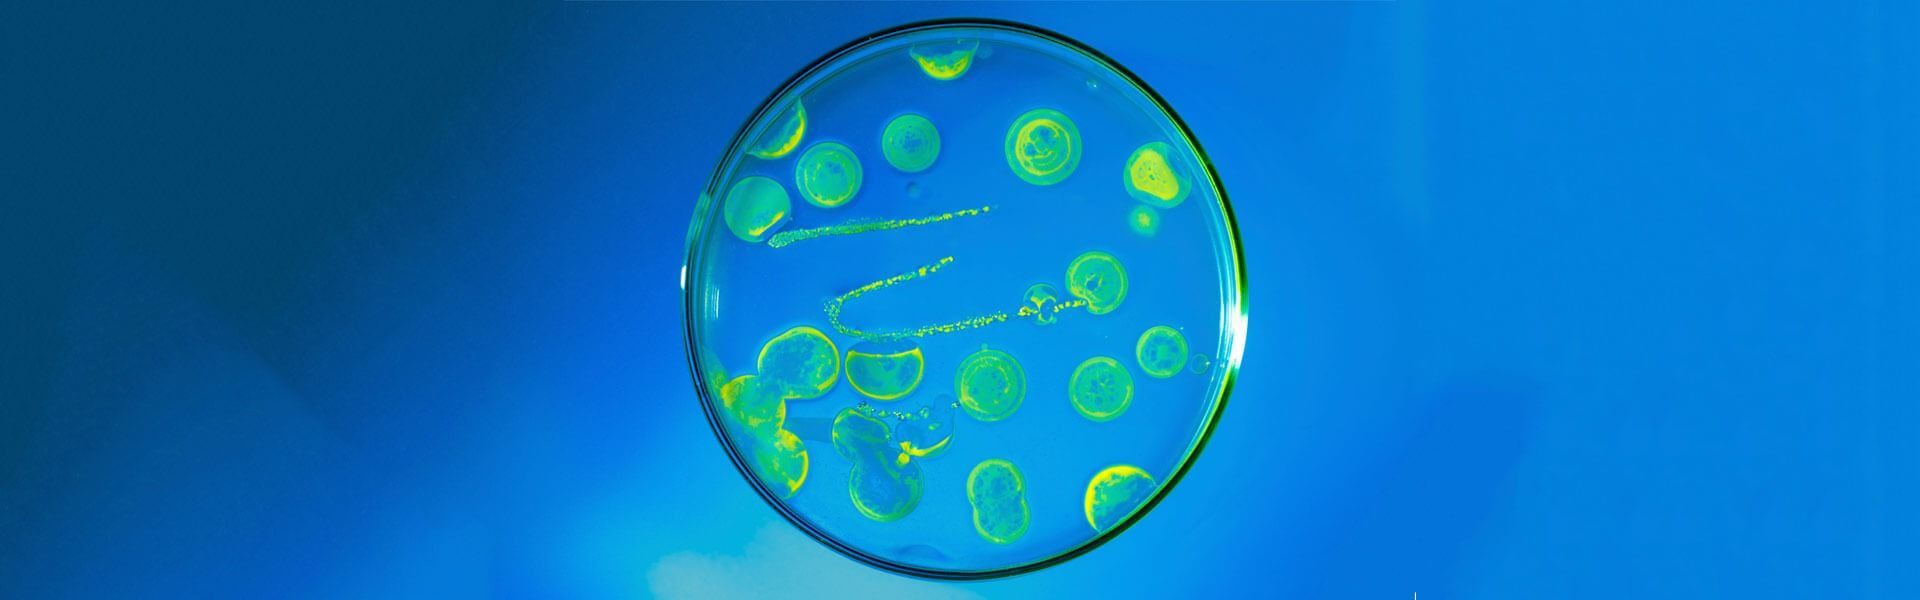
Anti-Infectives Market Worth Us$ 180.25 Billion by 2027

Anti-Infectives Market Worth Us$ 180.25 Billion by 2027
A new study titled “Anti-infectives MarketSize 2022”, published by Market Statsville Group (MSG), provides information on regional and global markets. MSG expects the global Anti-infectives market will showcase an impressive CAGR from 2022 to 2030. The comprehensive research report on the Anti-infectives market offers valuable insights, shedding light on the market dynamics, value chain analysis, regulatory framework, emerging investment hotspots, competitive landscape, regional landscape, and exhaustive market segments.
This report contains the historic, present, and forecast analysis of the Anti-infectives market at segmental, regional, and country-level, including the following market information:
Global Anti-infectives Market Revenue, 2018-2021, 2022-2030, (US$ Millions)
Global Anti-infectives Market Sales Volume, 2018-2021, 2022-2030, (Units)
Share of the top five Anti-infectives companies in 2021 (%)
Request Sample Copy of this Report: https://www.marketstatsville.com/request-sample/anti-infectives-market
Market Statsville Group™ has surveyed the Anti-infectives manufacturers, suppliers, distributors, and industry experts in its latest industry report. Also, the report provides a piece of in-depth information on the current strategies and opportunities adopted by the market players at a global and domestic level. This will assist the vendors/clients, policymakers, stakeholders, investors, and newcomers, in seeking information on the Anti-infectives market in seizing opportunities, pinpointing important tactics, and gaining an edge over its peer competitors.
The report further discusses a detailed segmental, regional, and country-level analysis of the Anti-infectives industry. It focuses on delivering an exhaustive market segmentation based on type, application, and end-use industries. The research report further presents a growth analysis of each segment to deliver an accurate calculation and future sales prospects within the timeframe 2022-2030. The analysis offers strategic insight and fruitful information to the readers, which will assist in capitalizing on the business offerings and expansion.
Direct Purchase Report: https://www.marketstatsville.com/buy-now/anti-infectives-market?opt=2950
Segments Covered in this report are:
Based on product, the anti-infectives market has been segmented into –
Antibiotics
Antivirals
Antifungals
Others
Based on indication, the anti-infectives market has been segmented into-
HIV Infection
Pneumonia
Respiratory Virus Infection
Sepsis
Tuberculosis
Others
Based on distribution channel, the anti-infectives market has been segmented into-
Hospital Pharmacy
Retail Pharmacy
Others
Based on route of administration, the anti-infectives market has been segmented into-
Oral
Topical
Parenteral
Others
Based on range, the anti-infectives market has been segmented into-
Narrow Spectrum
Broad Spectrum
Based on end-users, the anti-infectives market has been segmented into-
Hospitals
Homecare
Specialty Clinics
Others
Regions Covered in this report are:
North America (Revenue: USD Million; 2017-2030)
US
Canada
Mexico
Europe (Revenue: USD Million; 2017-2030)
Germany
France
U.K.
Italy
Russia
Nordic Countries
Benelux
Rest of Europe
Asia Pacific (Revenue: USD Million; 2017-2030)
China
Japan
South Korea
Southeast Asia
India
Rest of Asia
South America (Revenue: USD Million; 2017-2030)
Brazil
Argentina
Rest of South America
Middle East & Africa (Revenue: USD Million; 2017-2030)
Turkey
Israel
Saudi Arabia
UAE
Rest of the Middle East & Africa
Competitor Analysis of the Global Anti-infectives Market
The report emphasizes presenting detailed information about the industry that can assist its vendors/clients in making prompt decisions, business strategies, and investment goals in their respective markets. The study entails an extensive portfolio of market players leading or excelling continuously in the global and regional markets.
Access full Report Description, TOC, Table of Figure, Chart, etc: https://www.marketstatsville.com/table-of-content/anti-infectives-market
The key companies covered in the market report are:
Abbott Laboratories Limited
Cipla Ltd.
Claris Life Sciences Ltd.
Glenmark Pharmaceuticals Ltd.
GlaxoSmithKline Pharmaceuticals Ltd.
Lupin Ltd.
Panacea Biotech Ltd.
Novartis AG
Pfizer Ltd.
Ranbaxy Laboratories Ltd.
Sun Pharmaceuticals Ltd.
Why do you need to purchase this report?
To understand the current market scenario and future growth opportunities in both established and emerging markets.
To gain insights across dominating and growing segments across all key geographies and countries.
It saves time for the vendors looking for an entry-level research study, as the report comprises a 360-degree analysis of the market, including market size and volume over the forecast period, factors impacting the market growth, regulations, investment pockets, SWOT analysis, import/export trends, and others.
Historical, current, and projected market size from both ends, value (US$ million) and volume (units).
To understand the strategies adopted by the market players, company dashboard, and ranking of the key market players occupying the leading position in the regional and domestic markets.
3-months of analyst support, along with the Market Estimate sheet (in excel)
Request For Report Description: https://www.marketstatsville.com/anti-infectives-market
Radical highlights of the report:
What is the market size and growth rate over the analysis period (2018-2030)?
What are the factors driving and obstructing the market growth, along with the key trends and upcoming opportunities in the market during the forecast period?
How much can incremental dollar investment opportunities be witnessed in the market during the forecast period?
How to excel in the market by analyzing various forecast factors, including SWOT, PORTER's, PESTEL analysis, business recommendations, regulatory framework, value chain analysis, supply-demand scenario, and impact of COVID-19 and strategies to regain the market growth.
Who are the prominent companies with their market positioning share, winning strategies, investment strategies, and growth planning in the industry?
Appreciate the creator